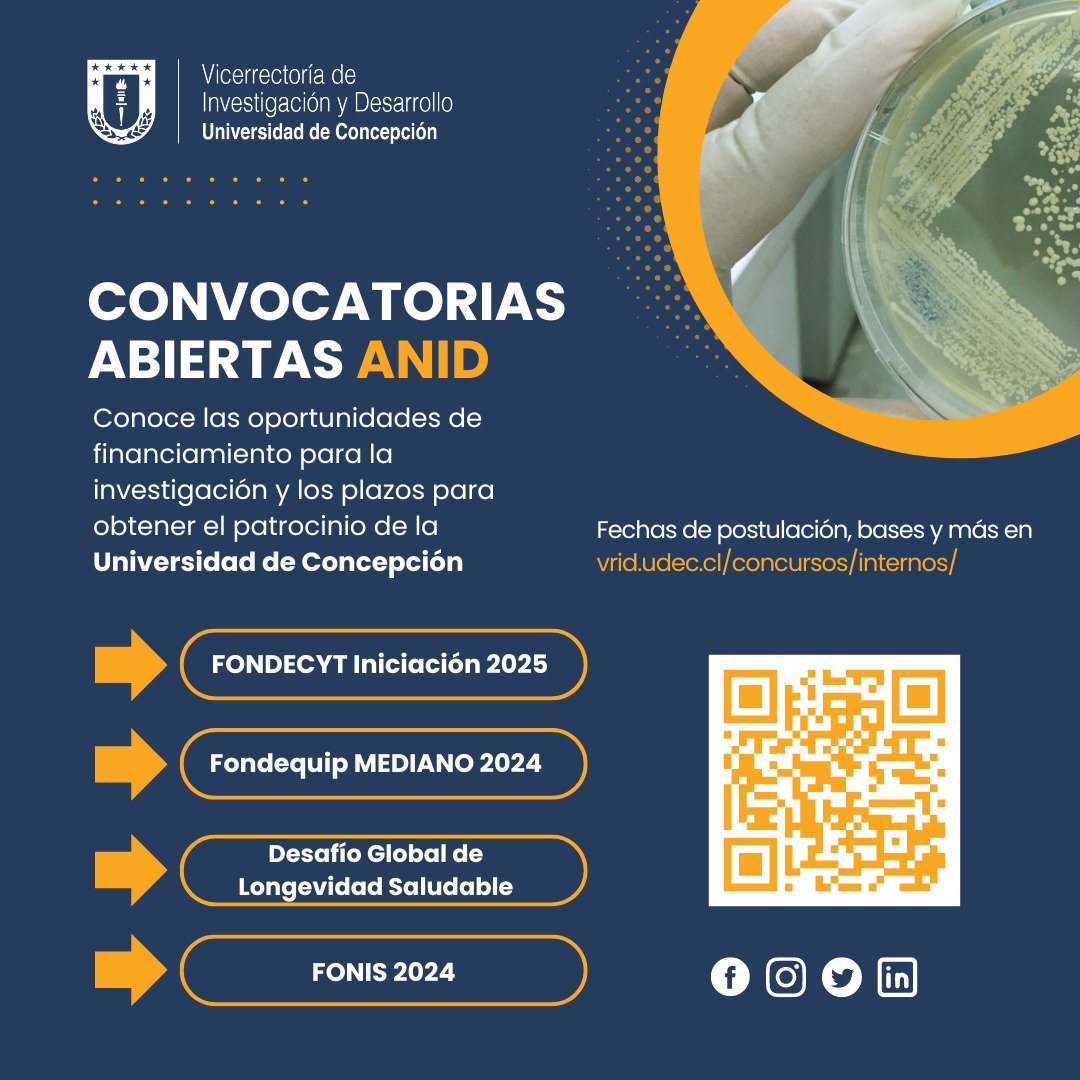
VRID UdeC tweet media

sebadubo retweetledi

📣 🧬 Les presentamos la nueva Sociedad Chilena de Genética Clínica @sochigec
Sociedad Chilena de Genética Clínica@sochigec
Español
sebadubo
397 posts

@se_du
Kinesiólogo, MSc, PhD y Académico de la @udeconcepcion













Limiting Overdistention or Collapse When Mechanically Ventilating Injured Lungs: A Randomized Study in a Porcine Model A randomized study about the best PEEP in ARDS using electrical impedance tomography (experimental). Low PEEP can be dangerous! 🔗 tinyurl.com/352ad2ym








Congratulations to Dr. @irene_telias for receiving the 2024 IMS Siminovitch-Salter Award for making outstanding scholarly contributions during her PhD program. ims.utoronto.ca/student-academ…